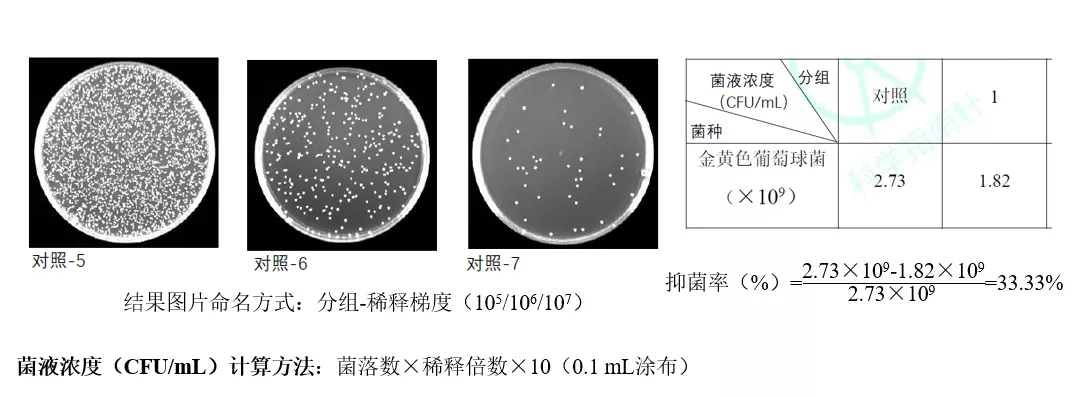

生物实验室简介
指南针郑州生物实验室,成立于2019年11月,位于河南省郑州市郑州高新技术产业开发区科学大道157号中国农业科学院棉花研究所,是杭州研趣信息技术有限公司的自营实验室之一。
总工作面积200余平方米,职工20人,全部具有本科及以上学历,其中研究生占比50%以上。
主要从事抗菌测试、细胞毒性及荧光成像、分子和蛋白测试、动物实验等业务,是一家具有综合性生物测试能力的专业检测机构。
实验中心始终坚持“客户第一”的服务态度,以“是否能为客户创造价值”为做决定的首要判断标准。
我们立志给客户提供专业、高效、可靠、更具性价比的分析测试服务,致力于打造一流的综合性分析服务中心,提升企业竞争力、提高客户满意度,成为科学研发和企业的首选服务商。
中心将继续不断加强实验室人才队伍建设,不断提高专业技术水平,不断完善实验室运营管理体系,不断优化服务质量。
实验中心详情
郑州生物实验室有细胞实验室、动物实验房、微生物实验室、分子蛋白实验室。
实验室有二氧化碳培养箱3台,激光共聚焦显微镜1台,扫描电镜1台,透射电镜1台,荧光倒置显微镜1台,流式细胞仪1台,生物安全柜3台,超净工作台4台,控温离心机3台,加热搅拌器2台,Bio-rad凝胶电泳仪2套,罗氏LightCycler 480 II 实时荧光定量PCR仪1台,SPF级动物房和普通清洁级动物房,瑞士TECAN多功能酶标仪1台,紫外分光光度计1台,生物膜干涉分子相互作用仪1台,超声波细胞粉碎机1台,电热恒温培养箱1台,高温高压灭菌锅1台等设备,可承接从体外(微生物、细胞和分子蛋白实验)至体内(动物实验)一整套技术服务。
设备介绍
1. 细胞实验
拥有细胞培养室2间:细胞室1和细胞室2。配备了十万级空气净化装置,设更衣间和洁净操作内间。
目前配备的主要设备有:二氧化碳培养箱3台,荧光倒置显微镜1台,生物安全柜2台,超净工作台3台,控温离心机2台,加热搅拌器2台,涡旋器2台,水浴锅和冰箱各2台。
细胞间可进行细胞系和原代细胞的培养,可开展实验类型有生物相容性检测、激光共聚焦显微镜成像、细胞流式检测等。

图1 细胞培养箱

图2 超净工作台和生物安全柜

图3 低温高速离心机(Eppendorf)
1.1 生物相容性检测—细胞毒性、活死染色等
细胞毒性检测是生物相容性测试的一种,检测药物或者新型材料在生物环境中的毒性情况,即通过检测材料或者药物对细胞的增殖或者生长的影响,来评价药物或材料的毒性或者活性,主要用于药物活性筛选、细胞增殖测定、细胞毒性测定、抗肿瘤药效测定等;常用MTT法或者CCK-8法检测,另外也可以通过Live/dead双染法进行细胞成像,更直观的记录细胞的存活情况。

图4 不同处理组细胞存活率计算
细胞死活染色成像:Calcein-AM是一种可对活细胞进行荧光标记的细胞染色试剂,Calcein-AM仅对活细胞染色,当其进入到细胞质后,酯酶会将其水解为Calcein留在细胞内,发出强绿色荧光;
核染色染料PI仅对死细胞染色,它不能穿过活细胞的细胞膜,只能穿过死细胞膜的无序区域而到达细胞核,并嵌入细胞的DNA双螺旋从而产生红色荧光;
因此通过细胞的死活染色可以观察到不同处理下细胞存活比例。
存活情况拍照:涉及荧光显微镜或激光共聚焦,Live/Dead试剂盒(Calcein-AM/PI双染)。

图5 细胞死活染色荧光显微镜(左)和激光共聚焦显微镜(右)拍照效果
1.2 激光共聚焦显微镜
Olympus最新激光扫描显微镜是一款高速、高灵敏度、高精确性,实现从宏观到微观全面观察成像的全新一代活细胞成像工具。
FV3000常规Galvo扫描可获得512X512分辨率下16fps的成像速度。搭载共振扫描振镜后,全视野成像速度高达30fps,在血流、心肌收缩等高速活细胞和活组织成像的同时,兼顾了多细胞大视野的检测应用,而对钙火花和钙震荡的成像速度则高达438fps。
可进行多通道的荧光共聚焦扫描拍摄,细胞内亚细胞定位2D和3D拍摄,如线粒体,溶酶体,高尔基体等亚细胞定位拍摄。

图6 Olympus激光共聚焦显微镜

图7 激光共聚焦显微镜拍摄案例
1.3 流式细胞仪 CANTO
流式细胞仪主机系统含三种以上波段的激光器 (488nm、633nm和405nm),系统包含荧光和散光 探测器,采用BD专利的立体空间激发和侧向反射 光路设计,不仅能最大限度降低激光和荧光信号的干扰,同时能将光信号在传导过程中的能量损失降 到最小,从而提高检测灵敏度。
可进行凋亡Annexin V/PI检测,周期PI检测,或者细胞表面标记抗体分选检测等。

图8 流式细胞仪(BD FACSCanto)

图9 流式检测案例
2. 蛋白和分子实验
(1) Bio-rad凝胶电泳仪
该设备可进行Western blot及核酸垂直电泳实验,Western,也称Western blot、Western blotting、Western印迹,是用抗体检测蛋白的重要方法之一。
检测材料或者药物对某个信号通路上蛋白靶点的影响,检测对细胞内某个特定蛋白的表达量。首先通过凝胶电泳将不同分子量大小蛋白进行分离,后续利用特异性抗体识别一定分子量大小的目的蛋白。

图4 凝胶电泳仪(BIO-RAD)
(2) Amersham lmager 600成像仪
改设备为Amersham lmager 600成像仪,用于凝胶和膜中蛋白质与DNA样品的数字图像的检测和分析,检测范围包括化学发光、荧光(紫外、红、绿、蓝)和白光成像。


图5 Amersham lmager 600成像仪
(3) 罗氏LightCycler 480 II 实时荧光定量PCR仪
LightCycler 480 II作为一款高通量实时荧光PCR仪器,能灵活兼容96个或384个样本同时进行检测,满足不同样本通量的客户需求,96孔和384孔温控模块可以灵活互换,不需要工程师到场,1分钟内完成,也无需后续仪器校正即可立即展开实验。
高分辨率熔解曲线(High-Resolution Melt, HRM)是一种用于突变扫描和基因分型的遗传学分析方法。HRM能够直接用染料而非标记探针准确地区分单碱基突变所带来的温度差异,这对实时定量PCR系统提出了前所未有的要求。
LightCycler® 480 II在加热模块和冷却元件之间引入的高效热平衡技术(Therma-BaseTM)使温控系统的热均一性获得了技术性的进步。
同时其精巧的光学系统设计通过光学元件及焦距的巧妙组合确保了整板信号激发的特异性与数据收集的一致性,从而消除了边缘效应。为开展高分辨率熔解曲线分析的研究者提供了一个理想的硬件平台。



图6 罗氏LightCycler 480 II 实时荧光定量PCR仪
(4) 瑞士TECAN多功能酶标仪 Spark
Spark多功能微孔板检测平台,可为几乎所有药物开发和前沿生命科学研究提供量身定制的解决方案。
研究人员可根据当前需求在此平台上自由配置功能模块,并可通过升级以获取未来所需的其它技术和特点。
光吸收模块:高速光栅检测器,在五秒内完成完整的吸收光谱扫描。革命性设计带来出色灵敏度和灵活性。
荧光模块:Spark的Fusion光路是首个在单次荧光测量中,将单色仪的灵活度与滤光片的灵敏度结合在一起的解决方案。Spark的发光模块可为 96孔、384孔和1,536孔的微光、闪烁和多色发光应用提供更高的灵敏度。
发光模块:前沿的发光光路设计,可以在保持灵敏度的同时记录光谱,让您获得出色的检测性能,同时又可为未来的发光应用未雨绸缪。
细胞成像模块:简单的完整环境控制,Spark将自动化培养箱、酶标仪及细胞成像功能整合在一起,为您自己及您所在的实验室提供了更多新的可能。

图7 多功能酶标仪(TECAN Spark)
3. 动物实验
随着生命科学的飞速发展,疾病发生发展的本质正在逐步被揭示,寻找高效、低毒、针对机理的新型药物已成为新的趋势。
建立和完善药物的系统药效学评价技术平台,是研发药物的前提和基础。科学指南针搭建药物临床前药效评价平台,按照国标标准建立疾病动物模型以满足客户的研发需求。
目前拥有SPF级动物房和普通清洁级动物房。其中SPF级可容纳大鼠120只,小鼠300只;清洁级可容纳大鼠100只,小鼠可容纳400只。可承接:封闭群大鼠、封闭群小鼠、近交系大鼠、近交系小鼠、免疫缺陷小鼠、基因编辑/自发突变小鼠等。



典型模型介绍:

案例展示:


案例展示:

4.微生物实验
拥有微生物实验设备:电热恒温培养箱1台、生化培养箱1台、超净工作台1台、生物安全柜1台、恒温振荡器1台、高温高压灭菌锅1台。
可承接抗菌测试、微生物染色及荧光成像、菌株构建等技术服务。

图8 左边恒温振荡器;右边电热恒温培养箱
(1) 抗菌性能定量检测
定量检测的原理是将一定量的测试菌株菌悬液接种于抗菌产品后,经过一定时间(根据菌株的生长周期来确定最佳的共培养时间)的共培养,测试样品抑制或杀死共培养液中的菌株;
而没有经过抗菌处理的对照样品接种测试菌株菌悬液后,接种菌不会受到抑制或杀死。
因此,根据测试菌数量的减少率可以定量评价测试样品的抗菌效果。
定量检测方法分为共培养+平板涂布计数法、MIC及MBC。
共培养+平板涂布计数法结果展示
MIC结果展示

(2) 抗菌性能定性检测
定性检测原理是通过将测试样品与测试菌株(菌液或者菌落)共培养一定时间后,观察菌液或者菌落生长有无受到抑制,以此来判断样品是否具有抗菌性能。
定性检测的优点是测试时间短、测试费用较低;但该测试不能定量得出抗菌产品抗菌活性的强弱,只能判定产品有无抗菌性能。
定性检测方法分为OD值法和抑菌圈法。
OD值测试结果展示


抑菌圈测试结果展示

(3) 细菌染色及荧光成像
测试样品与测试菌株作用后,通过相应染色试剂染色及成像,观察荧光变化情况即可判断出样品对于测试菌株的影响。

我们是由一群85后硕博创办的科研服务平台,提供各类科研测试服务,每天收到的测试样品来自各地,种类繁多,数量极大。若您对我们的服务不满意,或对测试结果有疑问,请果断联系我们或者直接拨打400-831-0631我们对每个数据及结果,会负责到底。
今天的郑州生物实验室就介绍到这里了,各位小伙伴还有哪些想要了解的实验室或者试验设备都可以在评论区留言,我们会为您依次介绍哦~
更多科研干货教程,可以点击下面链接获取哦~
郑州生物实验室是一家提供抗菌测试、细胞毒性分析、荧光成像等生物技术服务的实验室,配备先进的设备如激光共聚焦显微镜和流式细胞仪。实验室强调客户价值,致力于打造高效、专业的分析服务中心。

2172

被折叠的 条评论
为什么被折叠?



